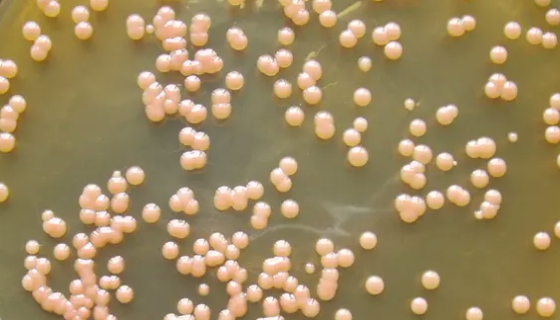
胶红酵母——牧草饲料发酵用菌种

植物乳植物杆菌的培养方法与实验内容及操作步骤!
植物乳杆菌(Lactobacillusplantarum)作...

Ana-1(小鼠巨噬细胞)的使用与处理及注意事项!
巨噬细胞是从循环的骨髓来源的单核细胞中分化出来的。在骨髓和之...

ATCC 21420 乳糖发酵短杆菌的培养及打管说明!
乳糖发酵短杆菌仅用于科学研究或者工业应用等非医疗目的不可用于...

用于抗丝状真菌研究的——短杆菌属
短杆菌属,放线菌目中的一属专性好氧、过氧化氢酶阳性、无芽孢的...
胶红酵母——牧草饲料发酵用菌种
胶红酵母是隐球酵母科、红酵母属真菌,其分布广泛,适应能力强,...

筑波拟酵母的特点与优势及培养与保存方法!
筑波拟酵母是Pseudozyma属的微生物,原产地为中国。担...

大鼠脑动脉血管内皮细胞的分离方法与质量检测!
大鼠脑动脉血管内皮细胞分离自脑动脉组织;脑动脉有成对的颈内动...

EBV-转化人淋巴细胞的培养与处理及注意事项!
EBV-转化人淋巴细胞的培养步骤与处理方法及注意事项有哪些?

ATCC 12757小白链霉菌的特点与优势及培养方法!
小白链霉菌孢子丝螺旋形,相当紧密,可达6—7圈。孢子椭圆形,...